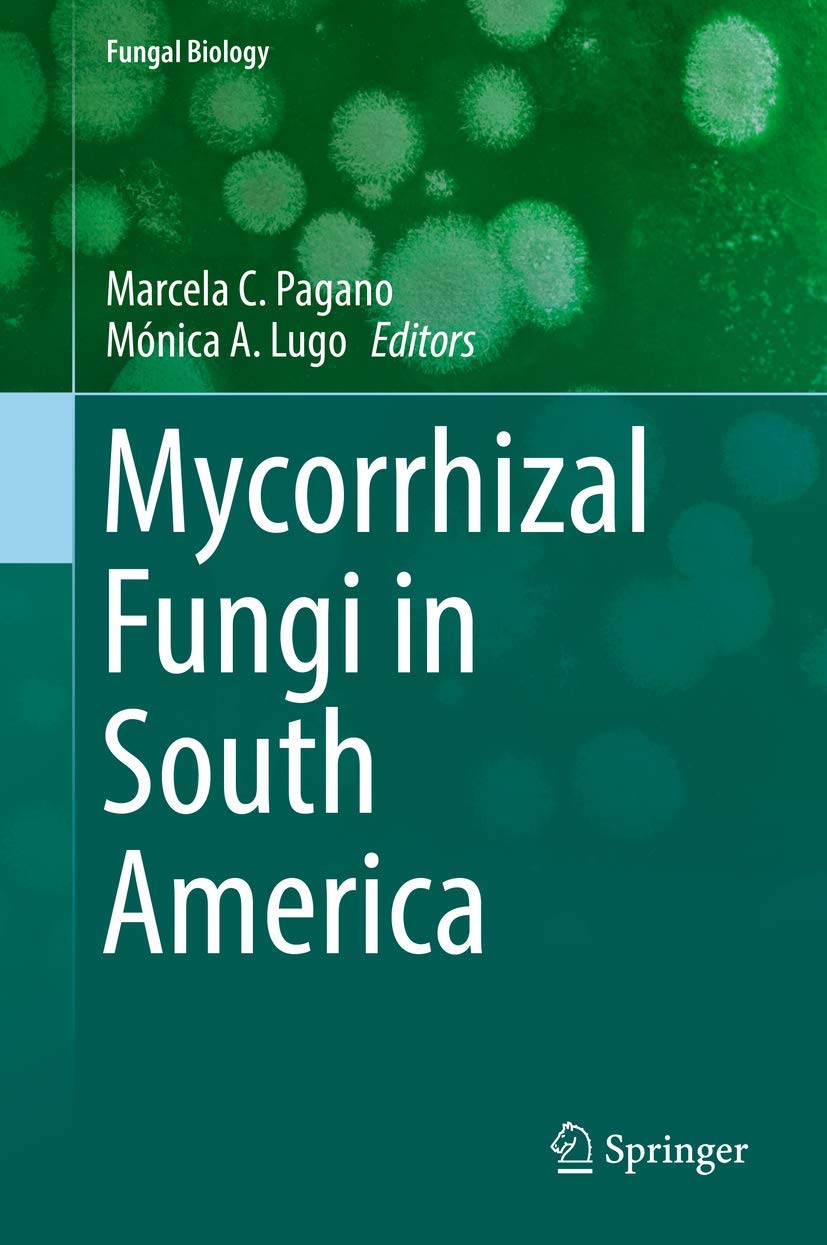

Title
Mycorrhizal Fungi in South America (Fungal Biology),Used
Sold by Ergodebooks, an authorized reseller.
Returns accepted within 30 days | support@ergodebooks.com
Shipping Information
- Free Standard Shipping — United States only
- Processing Time: 1–3 business days
- Estimated Delivery: 3–5 business days after dispatch
- Double-boxed, fully insured & discreetly packaged
- Tracking number sent via email once dispatched
- Orders over $250 require signature upon delivery. Taxes calculated at checkout.
Returns & Refund
Returns accepted within 30 days of delivery.
Damaged or Defective Item
Free return shipping + replacement or full refund
Wrong Item Received
Free return shipping + replacement or full refund
Change of Mind
Return shipping at customer's expense · 25% restocking fee applies
This new book shows the work done by researchers dedicated to the study of different mycorrhizas types, the fungal species associated and their distribution influenced by geographical and environmental factors among the different South American biogeographic regions. The exclusive biotic and abiotic characteristics delimit natural ecosystems with uniques biological communities, where mycorrhizologists have investigated plant symbioses in those ecosystems for decades, providing data from Venezuelan Great Savannah, Andes, Puna, Chaco, Caatinga, Monte, Atlantic Forest, Marginal Forest, Cerrado, Patagonia, Yungas, Rainforest, AndeanPatagonian Forests, and Antarctic section. In these environments, different mycorrhizal associations (arbuscular / ericoid / orchidoid / ectomycorrhizal / mycoheterotrophic) are present in herbaceous plants, shrubs, and trees. Mycorrhizal associations were studied from different researching points of view (biodiversity, biological invasions, biotic / abiotic disturbances, altitudinal variations, seasonal changes, land uses). The aim of this Book is to compile research on mycorrhizal fungi and their associations in environments of South America, throughout the synthesis of information from natural and anthropogenic related environments. The book focuses in different bioregions of South America from tropical areas to the southern cone, and it will be useful to those who work on plantfungal interactions in different vegetation types and in agricultural lands from South America and worldwide.
⚠️ WARNING (California Proposition 65):
This product may contain chemicals known to the State of California to cause cancer, birth defects, or other reproductive harm.
For more information, please visit www.P65Warnings.ca.gov.

